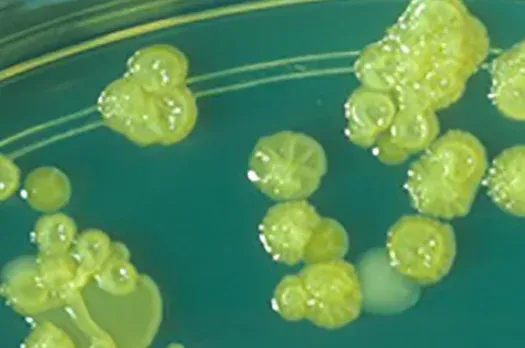

Ngày 3/01/2024, Cơ quan An toàn thực phẩm Vương quốc Anh xứ Wales và Bắc Ai-len đã yêu cầu Công ty hàng tiêu dùng Reckitt của Anh thu hồi 2 sản phẩm sữa công thức Nutramigen LGG Giai đoạn 1 và Giai đoạn 2 cho trẻ sơ sinh do xét nghiệm dương tính với vi khuẩn Cronobacter sakazakii.
Lô sữa công thức Nutramigen LGG Giai đoạn 1 bị thu hồi có mã lô: ZL3F7D, loại 400g có hạn sử dụng đến ngày 01/7/2025; các lô sữa Nutramigen LGG Giai đoạn 2 bị thu hồi có mã lô: ZL3FAA và ZL3FDM, loại 400g có hạn sử dụng đến ngày 01/7/2025. Công ty Reckitt cũng cam kết các lô sữa có các mã lô khác không bị ảnh hưởng và vẫn an toàn khi sử dụng.
Vi khuẩn Cronobacter sakazakii là gì?
Vi khuẩn được đặt theo tên họ Tiến sĩ Riichi Sakazakii (1920-2002), một nhà phân loại vi khuẩn người Nhật đã phát hiện một biến chủng có sắc tố màu vàng của Enterobacter cloacae và đã được đổi tên sau khi các thử nghiệm lai hóa DNA cho thấy nó là một loài riêng biệt. Trong nhiều năm, nó đã được phân loại như Enterobacter sakazakii nhưng kiểu phân tử gần đây đã cho thấy thực ra có 4 loài, một genomospecies và hai subspecies đã được xếp vào một chi mới (Cronobacter) trong họ Enterobacteriaceae. Cronobacter sakazakii có liên quan đến tỷ lệ mắc bệnh viêm màng não và viêm ruột hoại tử ở trẻ sơ sinh – rất có thể do sự nhiễm bẩn sau chế biến sữa công thức hoặc thức ăn cho trẻ sơ sinh.
Cronobacter phát triển trong phòng thí nghiệm. Ảnh: CDC Hoa Kỳ
Vi khuẩn Cronobacter sakazakii là các vi khuẩn gram âm, hình que, có thể di động, không hình thành bào tử. Có thể phát hiện vi khuẩn Cronobacter sakazakii trong môi trường tự nhiên, chúng có thể sống sót trong thời gian dài trong thực phẩm có độ ẩm thấp. Trên thực tế, đã phân lập được vi khuẩn Cronobacter sakazakii từ sữa bột trẻ em, sữa trẻ em hoàn nguyên và dụng cụ dùng để pha sữa trẻ em, nên vi khuẩn này đặc biệt nguy hiểm đối với trẻ sơ sinh.
Cronobacter sakazakii cũng được phát hiện trong sữa bột, trà thảo mộc và tinh bột, cũng như protein dạng bột và thực phẩm bổ sung. Đã phân lập được vi khuẩn này từ các cơ sở chế biến thực phẩm và đôi khi ở những nơi như nước cống.
Vi khuẩn Cronobacter sakazakii có thể gây nhiễm trùng vết thương hoặc nhiễm trùng đường tiết niệu ở mọi độ tuổi. Ở người trưởng thành và người cao tuổi suy giảm miễn dịch. Vi khuẩn này có thể dẫn đến nhiễm trùng máu.
Theo Trung tâm Kiểm soát và Phòng ngừa Dịch bệnh Hoa Kỳ (CDC), Cronobacter sakazakii là một loại vi khuẩn được tìm thấy trong môi trường tự nhiên. Những vi khuẩn này có thể sống trong thực phẩm khô, chẳng hạn như: sữa bột dành cho trẻ sơ sinh, trà thảo mộc, tinh bột, sữa công thức dạng bột không vô trùng và trong quá trình bảo quản tại nhà hoặc ô nhiễm tại các cơ sở chế biến sản phẩm.
Tại nhà : Có thể vô tình nhiễm Cronobacter trong sữa công thức dạng bột sau khi mở hộp đựng. Cronobacter có thể sống trên các bề mặt như bàn bếp, bồn rửa và trong nước. Cronobacter có thể xâm nhập vào sữa công thức dạng bột theo những cách sau:
- Nếu đặt nắp hoặc muỗng sữa công thức lên bề mặt bị ô nhiễm và sau đó chạm vào sữa.
- Nếu trộn sữa công thức với nước bị ô nhiễm hoặc trong chai bị ô nhiễm.
Cronobacter cũng có thể xâm nhập vào sữa bột dành cho trẻ sơ sinh tại cơ sở chế biến thông qua các thành phần bị ô nhiễm hoặc chạm vào bề mặt bị ô nhiễm.
Tại cơ sở chế biến : Cronobacter có thể xâm nhập vào sữa bột dành cho trẻ sơ sinh theo những cách sau:
- Nếu nhà sản xuất sử dụng các thành phần bị ô nhiễm để làm sữa công thức.
- Nếu bột sữa công thức chạm vào bề mặt bị ô nhiễm.
Trẻ nhỏ dễ nguy kịch nếu uống sữa bột nhiễm Cronobacter
Nhiễm Cronobacter rất hiếm gặp nhưng chúng có thể đe dọa tính mạng trẻ sơ sinh. Nhiễm trùng ở trẻ sơ sinh thường xảy ra trong những ngày hoặc tuần đầu tiên của cuộc đời. Khoảng 2 đến 4 trường hợp được báo cáo cho CDC Hoa Kỳ mỗi năm nhưng con số này có thể không phản ánh số lượng ca bệnh thực sự. Đó là bởi vì hầu hết các bệnh viện và phòng thí nghiệm không bắt buộc phải báo cáo tình trạng nhiễm Cronobacter cho sở y tế.
Nhóm Trẻ sơ sinh dễ nhiễm bệnh bao gồm:
- Trẻ sơ sinh dưới 2 tháng tuổi. Những trẻ sơ sinh này có nhiều khả năng bị viêm màng não nhất nếu chúng bị bệnh do Cronobacter.
- Trẻ sơ sinh sinh non.
- Trẻ sơ sinh có hệ miễn dịch yếu.
Cronobacter có thể gây nhiễm trùng huyết, gây phù lớp lót xung quang não và tủy sống (viêm màng não). Các biến chứng của nhiễm Cronobacter ở trẻ sơ sinh có thể bao gồm: áp xe não, chậm phát triển, suy giảm vận động và tử vong.
Các triệu chứng liên quan đến nhiễm trùng Cronobacter ở trẻ sơ sinh có thể bao gồm bú kém, khó chịu, thay đổi nhiệt độ, vàng da, thở khò khè hoặc cử động cơ thể bất thường. Một số trẻ sơ sinh cũng có thể bị co giật. Cha mẹ nên đưa trẻ sơ sinh có những triệu chứng này đến cơ sở y tế càng sớm càng tốt.
Tiến sỹ Vũ Đức Chiến
Viện Công nghiệp thực phẩm
Tài liệu tham khảo
Chia sẻ bài viết
- Đoàn Cán Bộ Viện Hàn lâm Khoa học tỉnh Quảng Tây, Trung Quốc đến thăm và làm việc tại Viện Công Nghiệp Thực Phẩm24/04/2026
- Tham tán Kinh tế và Thương mại Israel đến Thăm và Làm việc tại Viện Công nghiệp thực phẩm21/04/2026
- Hội thảo Ứng dụng Vi sinh vật Biến đổi Gen trong Sản xuất Công nghiệp15/04/2026
- Cơ quan Quản lý Thực phẩm Singapore (SFA) thu hồi rượu sake Sparkling Mio Premium (Hồng) do lo ngại về nguy cơ ảnh hưởng đến sức khỏe thận07/04/2026
- Tọa đàm Xây dựng Chương trình Khoa học Công nghệ và Đổi mới sáng tạo lĩnh vực Công Thương30/03/2026
